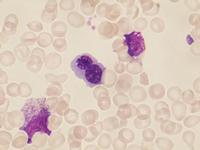
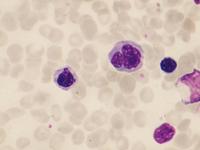

Als Folge der Hemmung der intrazellulären Tubulinsynthese findet man hier bei Knochenmarkpunktion etwa eineinhalb Tage nach Vincristin-Applikation im Knochenmark deutlich vermehrt Normoblasten, die im Metaphasestadium arretiert sind. Man erkennt, dass die Chromatinfäden kurz und dick erscheinen. Die Einschnürung in Kernmitte lässt vermuten, dass hier eine Anordnung der Chromosomen zur Äquatorialplatte begonnen hatte (Objektiv 100x Öl).

|
|
|
|